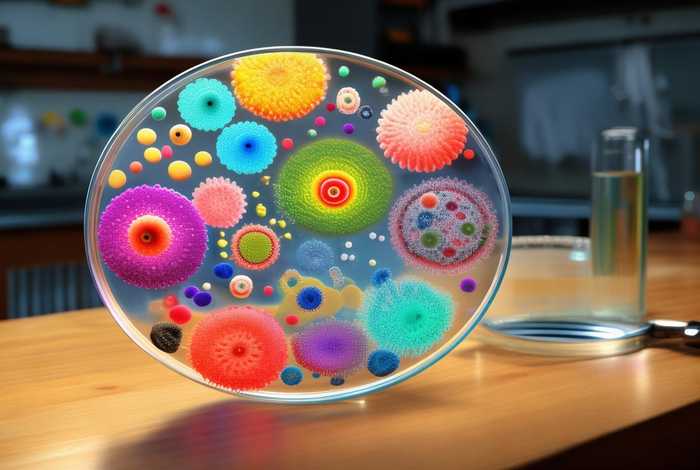
生活中用到的微生物（生活中用到的微生物种类）

生活中用到的微生物(生活中用到的微生物种类) ,对于想学习百科知识的朋友们来说,生活中用到的微生物(生活中用到的微生物种类)是一个非常想了解的问题,下面小编就带领大家看看这个问题。
看不见的魔法师:揭秘日常生活中的微生物盟友
你是否想过,每天清晨的那杯酸奶、面包里的蓬松气孔,甚至伤口愈合时的微妙变化,背后都藏着一群“隐形工程师”?它们微小到肉眼不可见,却以惊人的力量参与着人类生活的每一幕。今天,让我们揭开生活中用到的微生物的神秘面纱,探索这些微小生命如何塑造我们的健康、美食与未来。
从酸甜的泡菜到醇厚的酱油,发酵食品的风味密码就藏在微生物的代谢活动中。乳酸菌是泡菜和酸奶的灵魂,它们将糖类转化为乳酸,抑制有害菌繁殖的同时赋予食物独特口感;酵母菌则是面包和啤酒的“魔法师”,通过发酵产生二氧化碳,让面团膨胀、酒液冒泡。

更令人惊叹的是,某些传统发酵工艺依赖霉菌的参与。例如,制作豆腐乳的毛霉、酿造酱油的米曲霉,它们分解大豆蛋白的能力远超现代工业技术。这些微生物不仅是味觉的缔造者,更是人类饮食文化的守护者。
人体肠道内栖息着数万亿微生物,它们构成的“第二大脑”直接影响免疫力与情绪。双歧杆菌和嗜酸乳杆菌是益生菌明星,能抑制致病菌、缓解腹泻,甚至通过“肠脑轴”改善焦虑。现代医学已将其制成益生菌补充剂,成为都市人的健康标配。
而大肠杆菌的“善恶两面性”更值得玩味:某些无害菌株帮助合成维生素K,但致病型却可能引发食物中毒。这提醒我们:微生物与人类的关系,永远是合作与博弈的微妙平衡。
在污水处理厂,硝化细菌默默将有毒氨氮转化为无害硝酸盐;堆肥中,放线菌分解木质素的速度堪比微型粉碎机。甚至石油泄漏时,科学家会投放石油降解菌,让它们“吃掉”污染物。
家庭中,含枯草芽孢杆菌的清洁剂能分解油污,比化学试剂更环保。这些案例证明:微生物不仅是自然的分解者,更是人类对抗污染的绿色武器。
青霉素的发现开启了抗生素时代,其生产者青霉菌拯救了无数生命。如今,基因工程菌被改造为“活体药厂”,例如用大肠杆菌生产胰岛素,成本仅为传统方法的1/10。
在抗癌领域,溶瘤病毒选择性感染肿瘤细胞,被誉为“智能生物导弹”。微生物的医药潜力,正不断刷新人类对生命的认知边界。
科学家已尝试用蓝藻制造生物燃料,用产电菌构建“泥土电池”。在太空探索中,耐辐射菌为人类移民火星提供线索。这些研究揭示:微生物或许是人类迈向星际文明的钥匙。
从舌尖到星空,微生物始终是人类最古老的盟友与最前沿的科技伙伴。它们教会我们谦卑:所谓“征服自然”,不如说是学会与这些微小生命和谐共处。下一次当你品尝发酵美食或服用益生菌时,不妨对这群“看不见的魔法师”道一声感谢——毕竟,地球的真正主人,或许从来都是它们。
以上是关于生活中用到的微生物(生活中用到的微生物种类)的介绍,希望对想学习百科知识的朋友们有所帮助。
本文标题:生活中用到的微生物(生活中用到的微生物种类);本文链接:https://yszs.weipeng.cc/sh/772440.html。